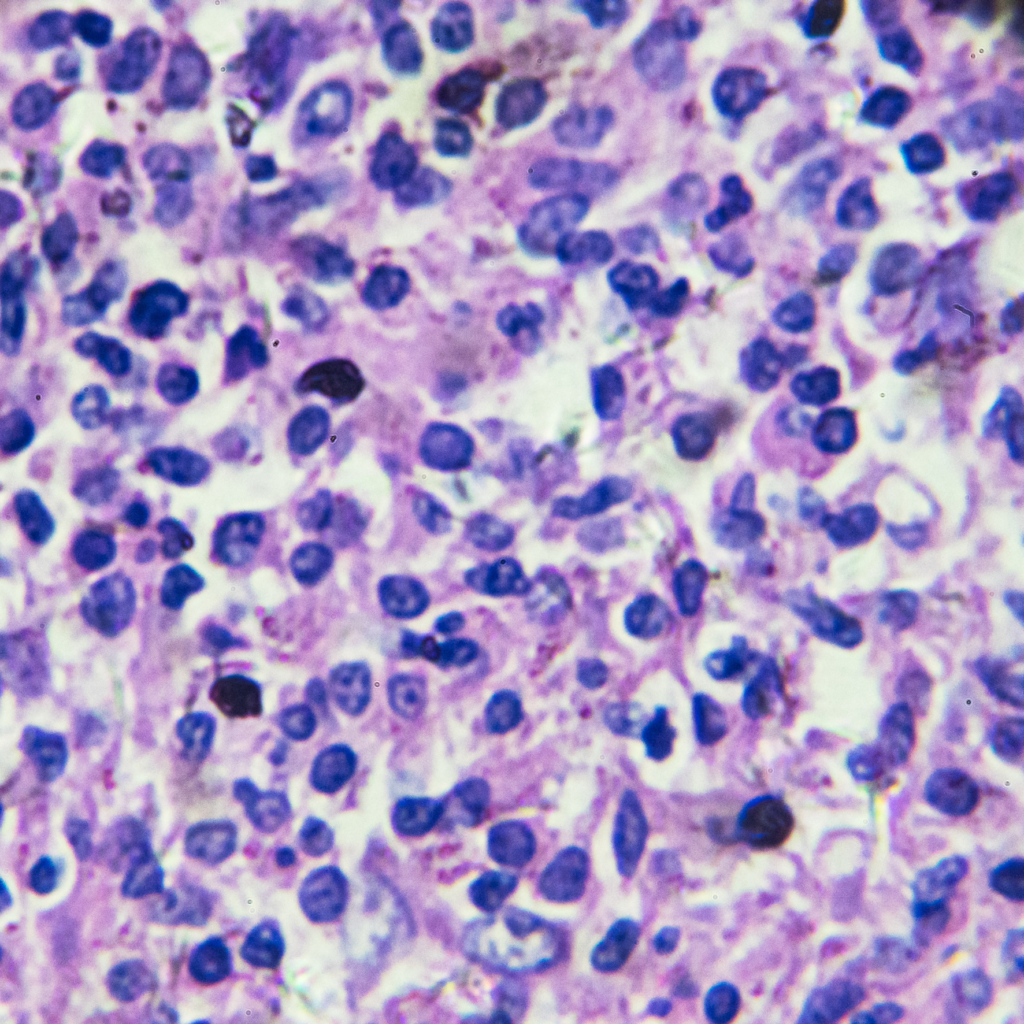

I. Definicja chłoniaka
A. Czym jest chłoniak?
Chłoniak to rodzaj nowotworu złośliwego, który powstaje w układzie chłonnym. Układ chłonny jest złożony z węzłów chłonnych, śledziony, szpiku kostnego i limfy. Chłoniaki powstają z komórek limfocytów, które są jednym z rodzajów białych krwinek.
B. Podstawowe informacje o chłoniaku
Chłoniaki są jednym z najczęstszych rodzajów nowotworów. Istnieje wiele różnych typów chłoniaków, które różnią się od siebie budową, szybkością wzrostu i sposobem leczenia. Zwykle rozpoczynają się od jednego węzła chłonnego, ale mogą także występować w różnych częściach ciała. Najczęściej dotyczą ludzi w wieku powyżej 60 lat, chociaż pojawiają się również u dzieci. Objawy chłoniaka mogą obejmować powiększenie węzłów chłonnych, gorączkę, nocne poty, utratę masy ciała i zmęczenie. Leczenie chłoniaka zwykle polega na chemioterapii, radioterapii i/lub terapii celowanej.
II. Znaczenie wczesnego rozpoznania
A. Dlaczego wczesne wykrycie jest kluczowe?
Wczesne rozpoznanie chłoniaka jest kluczowe, ponieważ pozwala na szybsze wprowadzenie odpowiedniego leczenia i zwiększa szanse na skuteczne wyleczenie. Im wcześniej zostanie zdiagnozowany chłoniak, tym lepsze są prognozy odnośnie skuteczności terapii i przeżycia pacjenta. Regularne badania kontrolne oraz świadomość objawów mogą pomóc w szybkim wykryciu chłoniaka.
B. Statystyki i dane epidemiologiczne
Chłoniaki stanowią około 4% nowotworów złośliwych i są jedną z głównych przyczyn zgonów związanych z nowotworami. Dane epidemiologiczne wskazują, że odsetek chorych na chłoniaka rośnie, a tendencja ta obserwowana jest na całym świecie. Wczesne rozpoznanie chłoniaka wydaje się być kluczowym czynnikiem w poprawie wyników leczenia i prognoz dla pacjentów z tą chorobą. Regularne badania przesiewowe oraz edukacja pacjentów na temat objawów i czynników ryzyka mogą przyczynić się do poprawy sytuacji epidemiologicznej związanej z chłoniakiem.
III. Chłoniak Hodgkina
A. Charakterystyka
Chłoniak Hodgkina jest jednym z dwóch głównych typów chłoniaka (drugim jest chłoniak nieziarniczy), odróżniającym się specyficznymi cechami histologicznymi. W chłoniaku Hodgkina występują tzw. komórki Reed-Sternberga, które są charakterystycznymi komórkami nowotworowymi. Chłoniak Hodgkina zazwyczaj rozwija się w jednym węźle chłonnym, ale może szybko przenosić się na inne obszary ciała.
B. Objawy i diagnostyka
Objawy chłoniaka Hodgkina mogą obejmować:
- Powiększenie węzłów chłonnych
- Gorączkę
- Nocne poty
- Zmęczenie
- Utratę masy ciała
- Świąd skóry
Do diagnostyki chłoniaka Hodgkina używa się różnych badań, takich jak biopsja węzła chłonnego, badania obrazowe (np. tomografia komputerowa, rezonans magnetyczny) oraz badania krwi (np. morfologia krwi, badanie poziomu markera nowotworowego – LDH). Ostateczna diagnoza jest ustalana przez patologa na podstawie analizy tkanki nowotworowej pobranej podczas biopsji. Wczesna i trafna diagnoza jest kluczowa dla skutecznego leczenia chłoniaka Hodgkina.
IV. Chłoniak nieziarniczy (NHL)
A. Podtypy i różnice
Chłoniak nieziarniczy (NHL) to szeroka grupa chłoniaków, które różnią się od siebie pod względem budowy, zachowania i reakcji na leczenie. W przeciwieństwie do chłoniaka Hodgkina, w chłoniakach nieziarniczych nie występują charakterystyczne komórki Reed-Sternberga. Istnieje wiele podtypów NHL, w tym chłoniak z komórek B, chłoniak z komórek T i chłoniak z limfocytów małych. Każdy z tych podtypów ma swoje charakterystyczne cechy kliniczne i histologiczne, co ma wpływ na plan leczenia i rokowanie.
B. Objawy i diagnostyka
Objawy NHL mogą być zróżnicowane i zależą od konkretnego podtypu oraz od tego, które obszary ciała są dotknięte. Najczęściej występujące objawy obejmują:
- Powiększenie węzłów chłonnych
- Gorączkę
- Utratę masy ciała
- Zmęczenie
- Świąd skóry
- Powiększenie narządów (np. śledziony, wątroby)
Diagnostyka NHL polega na pobraniu próbki tkanki z węzła chłonnego lub innego dotkniętego obszaru do badania histopatologicznego. Dodatkowe badania, takie jak tomografia komputerowa, rezonans magnetyczny, badanie krwi i badanie markera nowotworowego (LDH), mogą być wykonywane w celu oceny zaawansowania i monitorowania choroby. Wczesna diagnoza i właściwe zidentyfikowanie podtypu NHL są kluczowe dla opracowania indywidualnego planu leczenia.
V. Objawy chłoniaka
A. Objawy ogólne
- Objawy systemowe: Chłoniak może wywoływać objawy systemowe, takie jak gorączka, która może być uporczywa i niezwiązana z żadną znaną infekcją. Nocne poty, zwłaszcza w nocy, mogą być uciążliwe i prowadzić do zaburzeń snu. Utrata wagi niezwiązana z dietą czy aktywnością fizyczną może być również objawem chłoniaka.
- Objawy miejscowe: Najbardziej powszechnym objawem chłoniaka jest powiększenie jednego lub większej liczby węzłów chłonnych. Mogą być one łatwo wyczuwalne pod skórą i mogą być bolesne lub bezbolesne, w zależności od rodzaju chłoniaka oraz lokalizacji węzłów chłonnych.
B. Objawy specyficzne dla lokalizacji
- Objawy skórne: W chłoniakach skóra może być zaatakowana, co prowadzi do objawów takich jak swędzenie, zaczerwienienie, wysypki lub guzki skórne. Chłoniaki skórne mogą również powodować owrzodzenia skóry, które mogą być bolesne i wyjątkowo uciążliwe.
- Objawy w jamie brzusznej: Chłoniak może dotyczyć narządów w jamie brzusznej, takich jak wątroba, śledziona, trzustka, czy jelita. Objawy w jamie brzusznej mogą obejmować obrzęk brzucha, bóle brzucha, nudności, wymioty, zaburzenia trawienne, a także powiększenie wątroby lub śledziony, które mogą być wyczuwalne podczas badania fizykalnego.
- Objawy w klatce piersiowej: Chłoniak obejmujący klatkę piersiową może prowadzić do objawów takich jak duszność, kaszel, ból w klatce piersiowej, guzki lub zmiany w miąższu płuc. Jeśli chłoniak dotknie miąższ serca, może to prowadzić do zaburzeń rytmu serca, duszności i obrzęku płuc.
VI. Metody diagnostyczne
A. Biopsja
Biopsja jest kluczowym badaniem diagnostycznym w przypadku podejrzenia chłoniaka. Polega na pobraniu fragmentu tkanki lub komórek chłoniaka w celu analizy pod mikroskopem. Istnieje kilka różnych technik biopsji, takich jak biopsja węzła chłonnego, szpiku kostnego, czy nawet biopsja otwarto-igłowa. Wynik biopsji pozwoli określić rodzaj chłoniaka oraz jego stopień zaawansowania.
B. Badania obrazowe (CT, PET, MRI)
Badania obrazowe są pomocne w diagnozowaniu chłoniaka, a także w określeniu jego zaawansowania i lokalizacji.
- Tomografia komputerowa (CT) – umożliwia uzyskanie szczegółowych obrazów narządów wewnętrznych i węzłów chłonnych.
- Pozytonowa tomografia emisyjna (PET) – pozwala na ocenę aktywności metabolicznej komórek nowotworowych, co pomaga określić rozległość choroby.
- Rezonans magnetyczny (MRI) – odzwierciedla bardziej szczegółowe obrazy w porównaniu do CT, co może być przydatne w ocenie chłoniaków mózgu, rdzenia kręgowego czy płuc.
Dokładne analizy wyników tych badań obrazowych wspólnie z wynikami biopsji mogą pomóc w ustaleniu dokładnej diagnozy i planowaniu dalszego leczenia chłoniaka.
VII. Testy laboratoryjne
A. Morfologia krwi
Badanie morfologii krwi jest rutynowym badaniem laboratoryjnym, które może pomóc w wykryciu nieprawidłowości, takich jak niedokrwistość, leukopenia, czy trombocytopenia. W przypadku chłoniaka, najczęstszą nieprawidłowością jest wzrost liczby krwinek białych – limfocytów.
B. Markery nowotworowe
Markery nowotworowe to substancje produkowane przez komórki nowotworowe lub organizm w odpowiedzi na obecność komórek nowotworowych. Testy na markery nowotworowe w przypadku chłoniaka stos uje się raczej u osób z ciężkim zaawansowaniem choroby. Obecność lub ilość określonych markerów nowotworowych może pomóc w diagnostyce i ocenie postępów leczenia. Jednym z najczęściej stosowanych markerów nowotworowych w przypadku chłoniaka jest LDH (dehydrogenaza mleczanowa). Wysoka wartośc LDH w surowicy krwi może wskazywać na zaawansowanie choroby, ze względu na obecność dużych ilości komórek nowotworowych. Inne przykłady to beta-2 mikroglobulina (β2M) i antygen CD20.
Dokładne analizy wyników tych testów laboratoryjnych w połączeniu z wynikami innych badań mogą pomóc w ustaleniu dokładnej diagnozy oraz planowaniu dalszego leczenia chłoniaka.
VIII. Czynniki genetyczne
A. Predyspozycje rodzinne
Istnieje pewne dziedziczne predyspozycje do rozwoju chłoniaka. Osoby, które mają historię rodzinną chłoniaka lub innych rodzajów nowotworów układu chłonnego, mogą być bardziej narażone na ryzyko zachorowania na chłoniaka. Badania genetyczne i historia rodziny mogą być istotne w identyfikowaniu potencjalnych predyspozycji do rozwoju tej choroby.
B. Mutacje genetyczne
Badania wykazały, że mutacje genetyczne mogą odgrywać istotną rolę w rozwoju chłoniaka. Mutacje w genach związanych z regulacją wzrostu komórek, procesem apoptozy (programowanej śmierci komórki) mogą sprzyjać rozwojowi chłoniaka. Przykłady genów, w których mutacje są często obserwowane w chłoniakach, to geny z rodziny białek BCL2, BCL6, MYC. Identyfikacja konkretnych mutacji genetycznych może być istotna w określeniu prognozy i planowaniu leczenia.
Badania genetyczne mogą być przydatne w identyfikacji osób z podwyższonym ryzykiem rozwoju chłoniaka oraz w personalizacji terapii w oparciu o specyficzne mutacje genetyczne.
IX. Czynniki środowiskowe
A. Ekspozycja na chemikalia
Ekspozycja na pewne chemikalia środowiskowe może zwiększać ryzyko rozwoju chłoniaka. Substancje chemiczne takie jak pestycydy, herbicydy, substancje przemysłowe czy rozpuszczalniki mogą być potencjalnymi czynnikami ryzyka. Praca w branżach związanych z ekspozycją na te substancje, a także narażenie na nie w codziennym środowisku życia, mogą wiązać się z większym ryzykiem wystąpienia chłoniaka.
B. Zakażenia wirusowe (EBV, HIV)
Zakażenia wirusowe, zwłaszcza wirusem Ebsteina-Barr (EBV) i wirusem HIV, są powiązane z niektórymi rodzajami chłoniaka. EBV to wirus, który jest związany z rozwojem limfomów, zwłaszcza u osób o obniżonej odporności. Zakażenie HIV zwiększa ryzyko wystąpienia chłoniaków związanych z wirusem HIV (limfoma Burkitta, limfoma z dużych komórek B), ponieważ wirus może prowadzić do upośledzenia układu odpornościowego.
W przypadku czynników środowiskowych, kluczowym jest unikanie narażenia na substancje chemiczne oraz zapobieganie zakażeniom wirusowym poprzez świadomość i odpowiednie środki ochrony. Regularne badania kontrolne i świadomość środowiskowych czynników ryzyka mogą pomóc w zapobieganiu chłoniakom.
X. Styl życia i inne czynniki ryzyka
A. Palenie papierosów
Badania wykazały, że palenie papierosów może zwiększać ryzyko wystąpienia chłoniaków, zwłaszcza chłoniaków nieziarniczych z komórek B oraz chłoniaków związanych z zakażeniem wirusem P. Jako że palenie papierosów jest związane z wieloma innymi poważnymi schorzeniami, takimi jak nowotwory płuc czy choroby serca, rzucenie palenia może obniżyć ryzyko rozwoju chłoniaka oraz poprawić ogólną kondycję zdrowotną.
B. Dieta i aktywność fizyczna
Dieta bogata w warzywa, owoce, pełnoziarniste produkty zbożowe oraz niskotłuszczowe produkty mleczne, a jednocześnie ograniczona w ilość tłuszczów nasyconych i tłuszczów trans, może pomóc w zmniejszeniu ryzyka rozwoju chłoniaka. Podobnie, regularna aktywność fizyczna może przyczynić się do obniżenia ryzyka chłoniaka poprzez utrzymanie zdrowej masy ciała i wzmocnienie układu odpornościowego.
Styl życia odgrywa istotną rolę w ryzyku rozwoju chłoniaka. Zmiana złych nawyków, takich jak palenie papierosów, oraz dostosowanie diety i regularna aktywność fizyczna mogą pomóc w zmniejszeniu ryzyka wystąpienia tej choroby.
XI. Metody leczenia
A. Chemoterapia
Chemoterapia jest jedną z głównych metod leczenia chłoniaka. Polega na podawaniu leków przeciwnowotworowych, które niszczą komórki nowotworowe lub hamują ich wzrost. Chemoterapia może być stosowana samodzielnie lub w połączeniu z innymi metodami leczenia, takimi jak radioterapia czy immunoterapia. Działania niepożądane chemoterapii mogą obejmować nudności, utratę włosów oraz osłabienie układu odpornościowego.
B. Radioterapia
Radioterapia wykorzystuje promieniowanie jonizujące do niszczenia komórek nowotworowych. Jest stosowana w leczeniu miejscowym chłoniaka, pomagając zmniejszyć rozmiar guza lub znosić objawy. Radioterapia może powodować działania niepożądane, takie jak zmęczenie, podrażnienie skóry w obszarze napromienianym oraz inne efekty uboczne związane z obszarem na jaki jest stosowana.
C. Immunoterapia
Immunoterapia to rodzaj leczenia, które angażuje układ odpornościowy pacjenta w zwalczanie komórek nowotworowych. W przypadku chłoniaka, immunoterapia może polegać na stosowaniu leków, które pomagają wzmacniać reakcję odpornościową przeciwko komórkom nowotworowym. Działania niepożądane immunoterapii mogą obejmować reakcje alergiczne, zmęczenie oraz problemy skórne.
XII. Terapie celowane
A. Nowoczesne leki
Terapie celowane to nowoczesne podejście do leczenia chłoniaka, które opiera się na identyfikacji konkretnych molekularnych i genetycznych cech komórek nowotworowych. Dzięki temu możliwe jest zastosowanie leków, które precyzyjnie oddziałują na te cechy, eliminując komórki nowotworowe i minimalizując działania niepożądane na zdrowe tkanki.
B. Przykłady i skuteczność
Przykłady terapii celowanych w leczeniu chłoniaka to:
- Terapie oparte na przeciwciałach monoklonalnych – leki takie jak rituksimab czy obinutuzumab działają na specyficzne antygeny obecne na powierzchni komórek nowotworowych, prowadząc do ich zniszczenia.
- Inhibitory kinazy tyrozynowej – leki takie jak imatynib czy dasatinib blokują aktywność białek kinazowych, które są istotne dla rozwoju chłoniaka.
- Inhibitory BTK (kinazy Tyrosyny Bruton) – leki takie jak ibrutinib czy acalabrutinib blokują specyficzną kinazę zaangażowaną w wzrost i przetrwanie komórek chłoniaka.
Skuteczność terapii celowanych może być znacząca u pacjentów, których chłoniak posiada określone cechy molekularne lub genetyczne. Dzięki precyzyjnemu oddziaływaniu, terapie celowane mogą wykazywać wysoką skuteczność w kontroli wzrostu nowotworu oraz minimalizowaniu skutków ubocznych, co przyczynia się do poprawy jakości życia pacjentów. Jednakże, skuteczność konkretnego leczenia może się różnić w zależności od indywidualnych cech chłoniaka oraz ogólnego stanu zdrowia pacjenta.
XIII. Przeszczep szpiku kostnego
A. Kiedy jest zalecany?
Przeszczep szpiku kostnego jest zazwyczaj zalecany w przypadkach zaawansowanego chłoniaka, który nie odpowiedział na inne formy leczenia, takie jak chemioterapia czy immunoterapia. Może również być brany pod uwagę u pacjentów, u których chłoniak powrócił po wcześniejszym leczeniu.
B. Proces i ryzyko
Przeszczep szpiku kostnegopolega na pobraniu zdrowych komórek szpiku kostnego od dawcy i wprowadzeniu ich do organizmu pacjenta w celu zastąpienia uszkodzonych lub zmutowanych komórek szpiku. Proces ten wymaga szczegółowej oceny zgodności tkankowej między dawcą a biorcą, aby uniknąć odrzucenia przeszczepu. Po przeszczepie, pacjent może być narażony na ryzyko infekcji, skutków ubocznych związanych z chemioterapią lub radioterapią podczas przygotowania do przeszczepu, oraz zespołu przeszczep przeciwko gospodarzowi (GVHD), w którym komórki nowo przeszczepione atakują tkanki organizmu pacjenta.
Przeszczep szpiku kostnego jest poważną procedurą, która może być skutecznym leczeniem dla niektórych pacjentów z zaawansowanym chłoniakiem, ale wiąże się również z ryzykiem powikłań. Decyzja o przeszczepie szpiku kostnego powinna być podejmowana indywidualnie, z uwzględnieniem stanu zdrowia pacjenta, zaawansowania choroby oraz innych czynników.
XIV. Wsparcie psychologiczne
A. Rola wsparcia psychicznego
Choroba nowotworowa, w tym chłoniak, może znacząco wpłynąć na zdrowie psychiczne i emocjonalne pacjentów. Wsparcie psychiczne odgrywa kluczową rolę w procesie leczenia, pomagając pacjentom radzić sobie z stresem, lękiem i depresją związanymi z chorobą, a także wspierając ich w podejmowaniu decyzji dotyczących leczenia i dbaniu o swoje zdrowie psychiczne.
B. Grupy wsparcia i terapie
Grupy wsparcia skupiające się na chłoniaku mogą zapewnić pacjentom możliwość dzielenia się doświadczeniami, uzyskania wsparcia od osób przeżywających podobne sytuacje i zdobycia informacji na temat leczenia oraz radzenia sobie z skutkami ubocznymi. Terapie indywidualne, takie jak terapia poznawczo-behawioralna, mogą pomóc pacjentom w radzeniu sobie ze stresem i negatywnymi emocjami związanymi z chorobą.
XV. Dieta i styl życia
A. Zalecenia dietetyczne
Pacjenci z chłoniakiem powinni skonsultować się z dietetykiem w celu opracowania odpowiedniej diety, która wesprze ich leczenie i zdrowie ogólne. Zaleca się spożywanie zrównoważonych posiłków zawierających dużą ilość warzyw, owoców, pełnoziarnistych produktów zbożowych oraz zdrowych źródeł białka, takich jak ryby, drób, tofu czy rośliny strączkowe. Ważne jest również unikanie wysoko przetworzonej żywności, nadmiaru soli i cukrów oraz tłuszczów nasyconych.
B. Aktywność fizyczna
Regularna umiarkowana aktywność fizyczna może przynieść wiele korzyści dla pacjentów z chłoniakiem, pomagając wzmocnić system odpornościowy, poprawić kondycję fizyczną i stan psychiczny oraz zmniejszyć ryzyko chorób współistniejących. Zaleca się regularne, łagodne ćwiczenia, takie jak spacery, joga, pływanie czy jazda na rowerze, zgodnie z rekomendacjami lekarza prowadzącego.
XVI. Rehabilitacja i powrót do zdrowia
A. Programy rehabilitacyjne
Po zakończeniu leczenia chłoniaka, pacjenci mogą skorzystać z programów rehabilitacyjnych, które pomagają im powrócić do pełnej sprawności fizycznej i funkcjonalności. Programy rehabilitacyjne mogą obejmować fizjoterapię, terapię zajęciową, terapię mowy i inne metody dostosowane do indywidualnych potrzeb pacjenta. Celem rehabilitacji jest złagodzenie skutków ubocznych leczenia, poprawa zdolności ruchowych, przywrócenie równowagi i koordynacji oraz poprawa jakości życia.
B. Monitorowanie zdrowia po leczeniu
Po zakończeniu leczenia chłoniaka ważne jest regularne monitorowanie zdrowia pacjenta w celu wykrycia ewentualnych nawrotów choroby lub skutków ubocznych leczenia. Regularne wizyty u lekarza prowadzącego oraz badania kontrolne, takie jak badania krwi, badania obrazowe i inne diagnostyczne procedury, mogą pomóc w śledzeniu stanu zdrowia i szybkim reagowaniu na ewentualne problemy.
XVII. Przyszłość leczenia chłoniaka
A. Badania i innowacje
- Aktualne badania kliniczne: Obecnie prowadzone są liczne badania kliniczne mające na celu poprawę skuteczności leczenia chłoniaka oraz zwiększenie przeżywalności pacjentów. Badania te obejmują testowanie nowych terapii, leków i metod diagnostycznych. Pacjenci, u których zdiagnozowano chłoniak, mogą wziąć udział w takich badaniach, jeśli będą spełniać określone kryteria uczestnictwa.
- Przyszłe kierunki badań: W przyszłości, badania nad leczeniem chłoniaka skupią się na rozwijaniu bardziej precyzyjnych terapii ukierunkowanych na określone molekularne aberracje występujące w chłoniakach. Bada się również nowe metody immunoterapii, takie jak terapie CAR-T, które mogą zwiększyć skuteczność leczenia i poprawić rokowanie pacjentów.
B. Terapie eksperymentalne
- Nowe metody leczenia: W celu poprawy skuteczności leczenia chłoniaka, opracowywane są nowe metody terapeutyczne, takie jak immunoterapia, terapia genowa, terapia celowana na poziomie molekularnym i terapia radioligandowa. Wykorzystanie tych eksperymentalnych terapii może prowadzić do lepszych wyników leczenia i dłuższej przeżywalności pacjentów.
- Przykłady innowacyjnych terapii: Przykładami innowacyjnych terapii stosowanych w leczeniu chłoniaka są terapia CAR-T, immunoterapia checkpointowa, terapia chimericznymi cząsteczkami receptorowymi, terapia monoklonalna i wiele innych. Te terapie wykorzystują najnowsze zdobycze nauki i technologii w celu skierowanego atakowania komórek chłoniaka, minimalizując jednocześnie wpływ na zdrowe komórki.
Przyszłość leczenia chłoniaka wydaje się obiecująca, ze względu na rozwój badań, innowacje i eksperymentalne terapie. Wprowadzenie nowych, bardziej skutecznych metod leczenia może przynieść nadzieję dla pacjentów z chłoniakiem, poprawiając ich rokowanie i jakość życia. Warto być świadomym aktualnych badań i terapii, które mogą dostarczyć pacjentom nowe możliwości leczenia.
XVIII. Podsumowanie
A. Najważniejsze informacje do zapamiętania
- Chłoniak to rodzaj nowotworu układu chłonnego, który powstaje z limfocytów.
- Istnieje wiele rodzajów chłoniaków, które różnią się pod względem agresywności, rozmieszczenia i cech molekularnych.
- Objawy chłoniaka mogą obejmować powiększone węzły chłonne, gorączkę, zmęczenie, utratę wagi i świąd skóry.
- Diagnoza chłoniaka opiera się na badaniach obrazowych, biopsji węzła chłonnego i analizie molekularnej.
- Leczenie chłoniaka może obejmować chemioterapię, radioterapię, immunoterapię, terapię celowaną lub transplantację komórek krwiotwórczych.
- Opieka po leczeniu, rehabilitacja i monitorowanie zdrowia są ważnymi elementami powrotu do zdrowia.
B. Wskazówki dla pacjentów i ich rodzin
- Ważne jest regularne monitorowanie swojego zdrowia i szybkie zgłaszanie niepokojących objawów lekarzowi.
- Wspieranie się nawzajem w trudnych momentach choroby może przynieść ulgę zarówno pacjentowi, jak i jego rodzinie.
- Pamiętajcie o znaczeniu zdrowej diety, regularnej aktywności fizycznej i odpoczynku dla zachowania dobrej kondycji zarówno fizycznej, jak i psychicznej.
- Zawsze pytajcie lekarza o wszelkie wątpliwości i starajcie się zdobyć wiedzę na temat chłoniaka, aby być świadomym procesu leczenia i opieki.
- Poszukiwanie wsparcia w grupach wsparcia dla pacjentów z chłoniakiem lub organizacjach zajmujących się tym tematem może pomóc w radzeniu sobie z chorobą.
Podsumowując, znajomość podstawowych informacji o chłoniaku, rzetelna opieka medyczna i wsparcie bliskich mogą pomóc pacjentom w skutecznym radzeniu sobie z chorobą i powrocie do zdrowia. Warto być świadomym swojej sytuacji, dbać o siebie i otaczać się wsparciem w trudnych chwilach.
XIX. Najczęściej zadawane pytania (FAQs)
A. Jakie są pierwsze objawy chłoniaka?
- Chłoniak może objawiać się różnymi symptomami, ale najczęstsze objawy to:
- Powiększenie węzłów chłonnych, zwykle bezbolesne
- Gorączka nieznanej przyczyny
- Utrata masy ciała
- Znużenie i osłabienie
- Świąd skóry
Warto zauważyć, że te objawy mogą być również związane z innymi schorzeniami, dlatego ważne jest skonsultowanie się z lekarzem w przypadku ich wystąpienia.
B. Jakie są szanse na wyleczenie?
- Szanse na wyleczenie chłoniaka zależą od wielu czynników, takich jak rodzaj chłoniaka, stadium choroby i ogólny stan zdrowia pacjenta.
- Niektóre rodzaje chłoniaków, zwłaszcza te o niskim stopniu agresywności, mają wysokie szanse na wyleczenie. Inne, bardziej agresywne chłoniaki, mogą być bardziej trudne do wyleczenia, ale nadal istnieją skuteczne terapie, które mogą przedłużyć życie pacjenta i poprawić jakość jego życia.
C. Czy chłoniak jest dziedziczny?
- W większości przypadków chłoniak nie jest dziedziczny. Chłoniak jest wynikiem zmian w genach limfocytów i nie jest przekazywany z pokolenia na pokolenie w sposób dziedziczny. Jednak istnieją rzadkie przypadki chłoniaka rodzinnych, które mogą być związane z pewnymi genetycznymi mutacjami. W przypadku wystąpienia wielu przypadków chłoniaka w rodzinie, warto skonsultować się z lekarzem genetykiem.
D. Jakie są najnowsze metody leczenia?
- Najnowsze metody leczenia chłoniaka obejmują:
- Immunoterapia, która wykorzystuje zdolności układu odpornościowego do zwalczania nowotworu.
- Terapia celowana, która atakuje specyficzne molekularne cele w komórkach nowotworowych.
- Terapia genowa, która wprowadza zmienione genetycznie komórki do organizmu pacjenta w celu zwalczania nowotworu.
- Terapia CAR-T, która polega na modyfikacji genetycznej limfocytów pacjenta i użyciu ich do atakowania komórek chłoniaka.
Te nowe metody leczenia przynoszą nadzieję na lepsze wyniki terapeutyczne i dłuższą przeżywalność pacjentów.
E. Jakie zmiany w stylu życia mogą pomóc w leczeniu chłoniaka?
- Niektóre zmiany w stylu życia mogą pomóc w leczeniu chłoniaka i poprawie ogólnego samopoczucia, takie jak:
- Zachowanie zdrowej diety, bogatej w świeże owoce, warzywa i produkty pełnoziarniste.
- Regularna aktywność fizyczna, dostosowana do indywidualnych możliwości pacjenta.
- Równoważenie aktywności fizycznej z odpoczynkiem i dbanie o sen o wystarczającej długości i dobrej jakości.
- Unikanie palenia tytoniu i nadmiernej konsumpcji alkoholu.
- Skonsultowanie się z lekarzem w sprawie diety i ćwiczeń, aby dostosować je do indywidualnych potrzeb i możliwości pacjenta.
Pamiętaj, że odpowiedzi na te pytania są ogólne i mogą się różnić w zależności od indywidualnej sytuacji pacjenta. Ważne jest skonsultowanie się z lekarzem, aby uzyskać indywidualne porady i informacje dotyczące Twojego konkretnego przypadku chłoniaka.